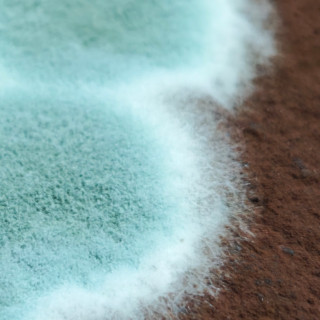

唱吧Android版
沃唱吧|
重新设置密码|
帮助中心|
联系我们|
加入唱吧|
防诈骗专栏|
商品防伪查询
北京酷智科技有限公司 ©2024 changba.com | 京ICP证110298 | 京ICP备11013291号-1 | 举报电话(24小时):022-25782593
京网文[2015]0390-170号 | 营业性演出许可证 | 京公网安备11010502025063号
视听许可证0110538 |
京公网安备11010502025063号
视听许可证0110538 |

北京酷智科技有限公司 ©2024 changba.com | 京ICP证110298 | 京ICP备11013291号-1 | 举报电话(24小时):022-25782593
京网文[2015]0390-170号 | 营业性演出许可证 |
 京公网安备11010502025063号
视听许可证0110538 |
京公网安备11010502025063号
视听许可证0110538 |